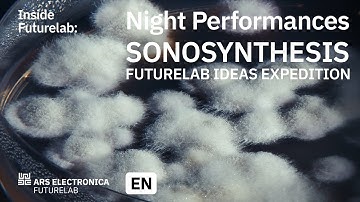
SonoSynthesis - Night Performances | Ars Electronica Futurelab

⬇ DOWNLOAD NOW
Kalau muncul iklan pop-up, tutup lalu klik tombol kembali
Download lagu Ars Electronica Mix: Inside Futurelab, Artificial Collectives secara gratis hanya untuk keperluan promosi. Dukung artis favorit kamu dengan membeli musik original di iTunes atau platform resmi lainnya.
 Ars Electronica Mix: Inside Futurelab AI meets Music
Ars Electronica Mix: Inside Futurelab AI meets Music
 Ars Electronica Mix LIVE: Inside Futurelab
Ars Electronica Mix LIVE: Inside Futurelab
 Ars Electronica Mix: Inside Futurelab - Origami Robotics with Matthew Gardiner
Ars Electronica Mix: Inside Futurelab - Origami Robotics with Matthew Gardiner
 Inside Futurelab: Deep Virtual insights
Inside Futurelab: Deep Virtual insights
 swarms+art | Ars Electronica Futurelab
swarms+art | Ars Electronica Futurelab
 Inside Futurelab: Ricercar
Inside Futurelab: Ricercar
 Inside Futurelab: 25th Anniversary Series – Episode 1 – Virtual Worlds
Inside Futurelab: 25th Anniversary Series – Episode 1 – Virtual Worlds
SonoSynthesis - Night Performances | Ars Electronica Futurelab
SonoSynthesis - Night Performances | Ars Electronica Futurelab